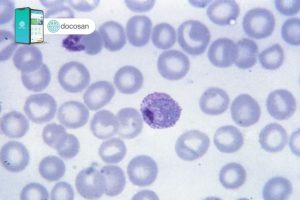

Bệnh sốt rét: Nguyên nhân, triệu chứng và cách điều trị
Sốt rét là một bệnh nhiễm trùng nghiêm trọng do muỗi truyền nhiễm. Nếu không được chẩn đoán và điều trị nhanh chóng, bệnh nhân có thể tử vong vì bệnh. Hãy cùng Docosan tìm hiểu rõ hơn về nguyên nhân, triệu chứng, cách điều trị và phòng ngừa bệnh ngay trong nội dung dưới […]